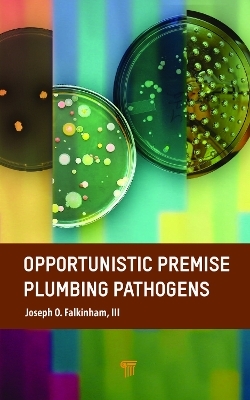
Opportunistic Premise Plumbing Pathogens - Joseph O. Falkinham III

Opportunistic Premise Plumbing Pathogens
Jenny Stanford Publishing (Verlag)
978-981-4968-40-9 (ISBN)
Legionella pneumophila, Pseudomonas aeruginosa, and Mycobacterium avium are water-borne opportunistic premise plumbing pathogens (OPPPs) that cause human disease of great economic cost. The incidence and prevalence of OPPP-disease caused by these three exemplary OPPPs is increasing at alarming rates.
As the first book-length review of OPPPs, this book describes the shared characteristics of the emerging group of water-borne pathogens that are normal inhabitants of drinking water systems and premise plumbing. It discusses the selective conditions of drinking water distribution systems and premise plumbing that have led to the emergence of OPPPs. The text also reviews the results of the studies that describe microbial adaptations leading to survival, persistence, and growth in drinking water distribution systems and premise plumbing.
Joseph O. Falkinham, III, received his PhD in microbiology from UC-Berkeley in 1969. Following four years in the US Air Force and a two-year postdoc, he accepted in 1974 a position as assistant professor at Virginia Tech, where he teaches genetics. His lab focuses on understanding the epidemiology, ecology, physiology, and genetics of the Mycobacterium avium complex—environmental opportunistic waterborne pathogens. Dr. Falkinham received the Gardner Middlebrook Award in 2003 for his contributions to mycobacteriology and was elected Fellow of the Royal Society for Public Health in 2015.
1. Introduction 2. Public Health Impacts of OPPPs 3. Characteristics of Premise Plumbing 4. Introduction to Established OPPPs 4.1. Legionella pneumophila 4.2. Pseudomonas aeruginosa and Burkholderia spp. 4.3. Mycobacterium avium Complex (MAC) 4.4. Amoebae and Protozoa 5. OPPPs as Amoeba-Resistant Microorganisms (ARMs) 6. Common Features and Sources of OPPPs 7. Introduction to Emerging OPPPs 7.1. Stenotrophomonas maltophila 7.2. Acinetobacter baumannii 7.3. Sphingomonas paucimobilis 7.4. Methylobacterium spp. 7.5. Segniliparus spp. 7.6. Cupriavidus spp. 8. Factors Influencing and Selection of OPPPs 9. Detection, Isolation, and Source Tracking OPPPs 10. OPPP Notification and Challenges to Current Water Treatment Practices 11. Management and Remediation of OPPPs
| Erscheinungsdatum | 15.03.2023 |
|---|---|
| Zusatzinfo | 13 Tables, black and white |
| Sprache | englisch |
| Maße | 152 x 229 mm |
| Gewicht | 458 g |
| Themenwelt | Naturwissenschaften ► Biologie ► Mikrobiologie / Immunologie |
| ISBN-10 | 981-4968-40-4 / 9814968404 |
| ISBN-13 | 978-981-4968-40-9 / 9789814968409 |
| Zustand | Neuware |
| Informationen gemäß Produktsicherheitsverordnung (GPSR) | |
| Haben Sie eine Frage zum Produkt? |
aus dem Bereich


